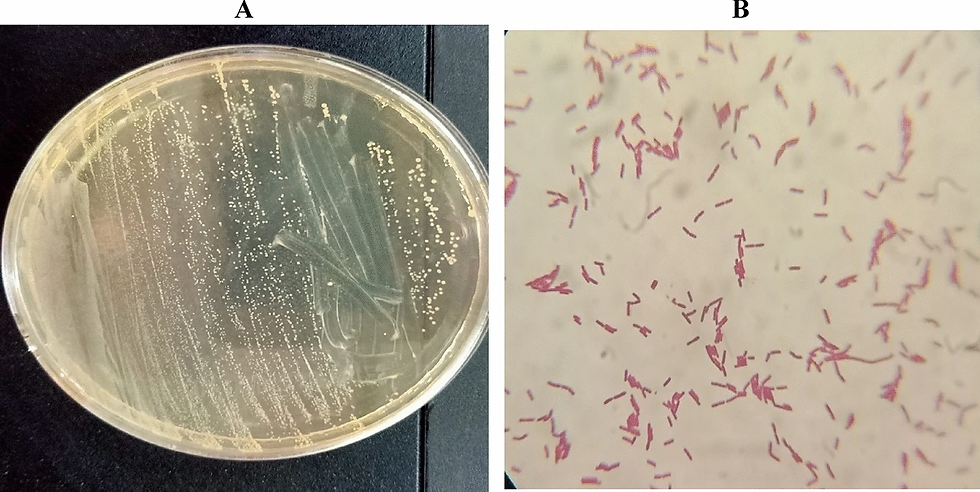
Lactiplantibacillus Plantarum

What Are the Uses of Lactiplantibacillus Plantarum?
- Stanislav M.

- Feb 14
- 5 min read
Updated: Feb 16
Lactiplantibacillus Plantarum (often still called Lactobacillus plantarum) is a friendly lactic acid bacterium best known from yogurt, pickles, and other fermented foods. Today, it is also an important “workhorse microbe” in agriculture, biofertilizers, soil health solutions, animal feed, and food processing.frontiersin+1
This article walks through its main practical uses with simple examples. For a fuller overview of how this microbe behaves in soil and across industries, see the pillar page “Lactiplantibacillus plantarum: Benefits, Functions, and Characteristics Across Industries.”
1. Helping Crops Grow: Uses in Agriculture and Biofertilizers
1.1 As a biofertilizer ingredient
Many modern biofertilizers and microbial blends include L. plantarum alongside Bacillus, yeasts, and other beneficial microbes.indogulfbioag+1
How it’s used in the field
Soil drench or through drip: Growers dilute a liquid microbial blend containing L. plantarum and apply it via irrigation.
With organic fertilizers or compost teas: LAB-based products are mixed into organic inputs so they break down faster and release nutrients more steadily.gardenculturemagazine+1
What it does in simple terms
Helps decompose organic matter, like crop residues and manures, making nutrients easier for roots to absorb.pmc.ncbi.nlm.nih+1
Produces natural acids that can “unlock” bound phosphorus and micronutrients in the soil.publishing.emanresearch+1
Competes with harmful microbes around the root, contributing to a healthier rhizosphere.
1.2 In multi-strain microbial blends (“EM-type” products)
L. plantarum is a core member of many “Effective Microorganisms”‑style products. For example, microbial blends like Micro-Manna include lactic acid bacteria (including L. plantarum), photosynthetic bacteria, and yeasts at about 1 × 10^8 CFU/ml.indogulfbioag+1
Practical uses
Soil revitalization: Applied to tired, compacted, or saline soils to rebuild biological activity and improve structure over time.
Crop kits: Used as part of integrated programs (seed treatment + soil drench + foliar) to boost overall plant vigor and reduce chemical input needs.
2. Improving Soil Health and Residue Breakdown
2.1 Faster composting and bokashi-style fermentation
Lactic acid bacteria like L. plantarum are excellent at fermenting organic materials.seedandknowledge+1
On-farm examples
Bokashi compost: Farmers and gardeners mix L. plantarum–rich inoculants with kitchen scraps, crop residues, or manures in airtight containers. The material ferments instead of rotting, then is buried or added to soil, where it finishes breaking down quickly.
Compost accelerators: LAB-based “starters” are sprayed on compost piles to speed up breakdown and reduce odors.
Benefits
Faster conversion of waste into usable organic fertilizer.
Less smell and fewer flies around manure or food waste piles.
More stable, nutrient-rich organic matter that feeds soil life.pmc.ncbi.nlm.nih+1
2.2 Supporting soil structure and nutrient cycling
By helping break down organic matter and producing sticky substances and acids, L. plantarum contributes indirectly to:
Better soil aggregation (crumb structure), which improves water infiltration and root penetration.
Smoother nutrient cycling, so nitrogen, phosphorus, and other elements are released in plant-friendly forms.publishing.emanresearch+1
A simple way to picture it: L. plantarum and other LAB act like a “starter culture” for your soil, waking up the biology that drives healthy nutrient flows.
3. Natural Support Against Plant Diseases
3.1 Suppressing harmful fungi and bacteria
L. plantarum produces lactic acid, antimicrobial peptides (bacteriocins), and sometimes biosurfactants that can slow down or block certain pathogens.frontiersin+2
Research on lactic acid bacteria in agriculture shows they can:
Reduce fungal diseases like Fusarium on cereals and horticultural crops.
Inhibit spoilage and disease organisms on fruits and vegetables.pmc.ncbi.nlm.nih+1
Practical examples
Seed or root dips: Seeds or seedlings dipped in a suspension containing L. plantarum before planting to protect them from early soil-borne infections.
Foliar sprays (in some programs): LAB-based sprays used alongside other biologicals to lower disease pressure on leaves and fruit surfaces.
While L. plantarum alone is not a full replacement for all fungicides, it adds a valuable biological layer of protection in integrated pest management.
3.2 Better silage and forage preservation
In forage production, L. plantarum is widely used as a silage inoculant.
Studies on soybean and amaranth silage show that adding L. plantarum:
Lowers pH faster.
Increases lactic acid content.
Improves protein preservation and overall fermentation quality.frontiersin+1
On-farm outcome
Dairy and livestock producers get:
More stable silage with less spoilage.
Better nutritional value, which supports animal performance and reduces feed losses.
4. Uses in Animal Nutrition and Health
4.1 As a probiotic or postbiotic in feed
L. plantarum is a well-established probiotic in animal nutrition.[frontiersin]
In poultry and livestock
Postbiotics (heat-killed cells and their metabolites from L. plantarum) have been tested as alternatives to antibiotic growth promoters in broiler chickens.
Results show improved gut health, better nutrient digestibility, stronger immune response, and improved growth and meat quality.[frontiersin]
In ruminants and pigs
L. plantarum from silage and supplements supports a balanced gut microbiota, helping animals use feed more efficiently and resist digestive upsets.frontiersin+1
This use connects back to soil: healthier animals mean better-quality manure, which returns to fields and feeds soil microbes, including LAB.
5. Uses in Food, Fermentation, and Bioproducts
Although your main interest may be agriculture and soil, many commercial uses of L. plantarum come from food and biotech, and they often tie back to farming systems.
5.1 Food fermentation and shelf-life extension
L. plantarum is widely used as:
A starter culture for fermented vegetables, dairy, cereals, meats, and plant-based drinks.pmc.ncbi.nlm.nih+1
A bio-preservative to keep food safer for longer by suppressing spoilage organisms and pathogens.frontiersin+1
This matters for agriculture because it:
Creates more stable markets for crops (e.g., vegetables and grains processed into high-value fermented products).
Reduces food losses post-harvest.
5.2 Human probiotic products
In the human health sector, L. plantarum is used in probiotic capsules, drinks, and yogurts to support digestion, immunity, and general well-being.frontiersin+1
While this is outside the field, it reinforces one key point: the same microbe that supports human gut health can also support “soil gut health” when applied correctly in agriculture.
5.3 Industrial enzymes and biosurfactants
Certain strains of L. plantarum are used industrially to produce:
Enzymes (amylases, glucosidases, lipases) for food processing and other applications.[pmc.ncbi.nlm.nih]
Biosurfactants with strong antimicrobial and antibiofilm activity that can be used in cleaning, coatings, and possibly crop protection formulations.frontiersin+1
These higher-value products can originate from agricultural feedstocks (grains, molasses, plant juices), creating new markets for farm outputs.
6. Emerging Uses: Biofertilizer R&D and Functional Crops
New research and projects are exploring more targeted uses of lactic acid bacteria like L. plantarum as plant inoculants:
EU-backed work on LAB-based biofertilizers for blueberries aims to increase yield and boost health-promoting compounds in the fruit, all while keeping biosafety standards high.[cordis.europa]
Reviews highlight LAB as promising tools for pesticide detoxification, heavy-metal bioremediation, and more advanced soil restoration strategies.publishing.emanresearch+1
As these technologies mature, farmers may see more crop-specific products where L. plantarum is selected not just for general soil health, but for specific benefits like improving fruit antioxidant content or helping plants cope with stress.
7. Bringing It All Together
Across agriculture, soil systems, and related industries, the main practical uses of
Lactiplantibacillus plantarum are:
In the soil: speeding up organic matter breakdown, improving nutrient availability, and supporting a healthy soil microbiome.
In biofertilizers: acting as a core member of microbial blends that revitalize soils, promote root growth, and reduce reliance on chemicals.
In plant protection: adding a natural layer of disease suppression against harmful fungi and bacteria, and improving silage preservation.
In animals and food: serving as a probiotic, postbiotic, and starter culture that links farm production to safe, high-value feed and food.frontiersin+2

Comments